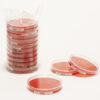

| Tên sản phẩm: | ReadyPlate CHROM CCA ISO303 20PC Merck |
| Tên gọi khác: | ChromoCult Coliform Agar |
| Code: | 1466890020 |
| Hãng – Xuất xứ: | Merck – Đức |
| Ứng dụng: |
– Được sử dụng rộng rãi trong phòng thí nghiệm trường học, viện nghiên cứu,.. – Được sử dụng để phát hiện tổng coliforms và E. Coli trong nước uống và mẫu thực phẩm chế biến |
| Tính chất: |
– Hình thể: dạng gel – Màu sắc: màu vàng |
| Bảo quản: | Từ +15°C đến +25°C |
| Quy cách: | Tấm 90 mm (20 tấm mỗi hộp) |
ReadyPlate CHROM CCA ISO303 20PC Merck
0 ₫
ReadyPlate CHROM CCA ISO303, sản xuất bởi hãng: Merck- Đức, code: 1466890020, tồn tại dưới dạng gel, màu vàng. Được sử dụng để phát hiện tổng coliforms và E. Coli trong nước uống và mẫu thực phẩm chế biến. Quy cách đóng gói: tấm 90 mm (20 tấm mỗi hộp)
Hãy là người đầu tiên nhận xét “ReadyPlate CHROM CCA ISO303 20PC Merck” Hủy
Sản phẩm tương tự
Hóa chất thí nghiệm
Hóa chất thí nghiệm
CAL Check™ chuẩn Clo thang cao, 0.00 và 4.00 mg/L HI96734-11 Hanna
Hóa chất thí nghiệm
Potassium iodate solution for 1000 ml, c(KIO₃) = 1/₆₀ mol/l (0.1 N) Titrisol®
Hóa chất thí nghiệm
Hóa chất thí nghiệm
Dung dịch hiệu chuẩn TDS 12.41 g/L (ppt) HI7036L chai 500ml Hanna
Hóa chất thí nghiệm
CAL Check™ Chuẩn Mangan Thang Thấp, 0 và 150 μg/L HI96748-11 Hanna
Hóa chất thí nghiệm
Dung dịch hiệu chuẩn Natri 2.3 g/l chai 500 mL HI7080L Hanna
Hóa chất thí nghiệm
Titriplex® III solution for 1000 ml, c(Na₂-EDTA 2 H₂O) = 0.01 mol/l Titrisol®

Đánh giá
Chưa có đánh giá nào.